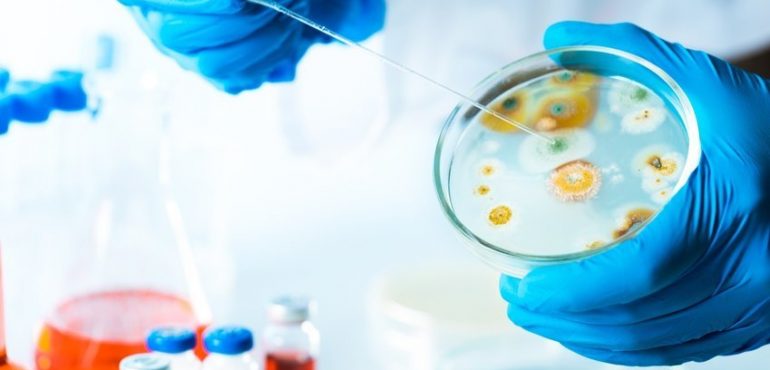

It is estimated that each year in the United States 2 million people become infected with bacteria that are resistant to one or more types of antibiotics, and at least 23,000 people will die because of these infections. This problem is being exacerbated by overuse of antibiotics for livestock and also in community clinical practice. This overuse, combined with the slow pace of novel drug discovery is a growing threat to public health. In response to this, Moffitt Cancer Center researchers have developed a novel mathematical method inspired by Darwinian evolution to use current antibiotics to eliminate or reduce the development of antibiotic-resistant bacteria.
According to the Centers for Disease Control, one of the core actions that can be taken to fight antibiotic-resistant infections is to improve the use of antibiotics that currently exist. One approach to achieve this is by using different combinations or sequences of antibiotics; however, given the high number of antibiotics in existence, it would be extremely difficult to experimentally identify the best combination or sequence of drugs.
Moffitt researchers overcame this problem by developing a novel mathematical approach to analyze antibiotic resistance. They showed that the ability of the bacterium E. coli to survive in antibiotics could be either promoted or hindered depending on the sequence of antibiotics given. They discovered that approximately 70 percent of different sequences of 2 to 4 antibiotics lead to resistance to the final drug.
"Our results suggest that, through careful ordering of antibiotics, we may be able to steer evolution to a dead end from which resistance cannot emerge," said Daniel Nichol, lead author and graduate student jointly in the Oxford University Department of Computer Science and Moffitt's Department of Integrated Mathematical Oncology.
"Our results can be easily tested in the laboratory, and if validated could be used in clinical trials immediately, as all of the compounds we studied are FDA approved and commonly prescribed," said Jacob G. Scott, M.D., senior author and member of Moffitt's Radiation Oncology and Integrated Mathematical Oncology Departments.
The researchers explained that their results also serve as a caution to healthcare workers, as the careless or random prescription of drugs that occurs could inadvertently lead to antibiotic resistance.
"While I'm an oncologist, the problem of the evolution of resistance to antibiotics is completely analogous to that of cancer's evolution of resistance to targeted therapy, and the mathematical model we've used can be applied to both situations. Our next efforts are jointly focused on targeted therapy in lung cancer as well as on validating our existing results in bacteria," said Scott.
The study was published online in the journal PLoS Computational Biology. Funding support was received through the Engineering and Physical Sciences Research Council (OUCL/DN/2013 and EP/I017909/1), the National Institutes of Health Loan Repayment Program, the National Cancer Institute Integrative Cancer Biology Program (U54 CA113007), the National Cancer Institute Physical Sciences in Oncology Centers (U54 CA143970), the Veterans Affairs Merit Review Program, the National Institutes of Health (AI072219-05, AI063517-07) and the Geriatric Research Education and Clinical Center VISN 10.
Source: H. Lee Moffitt Cancer Center & Research Institute. (2015, October 9). Novel theoretical approach to reduce antibiotic resistance: The combination and sequence of antibiotics can promote or hinder the development of antibiotic-resistant bacteria. ScienceDaily. Retrieved October 14, 2015 from www.sciencedaily.com/releases/2015/10/151009155413.htm